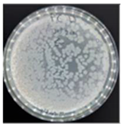
Materproc 11 00004 i002
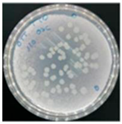
Materproc 11 00004 i003

Surface Treatments on Additively Manufactured Ti6Al4V Parts for the Formation of Photocatalytic Nanostructured Surfaces with Antibacterial Properties †
Abstract
:1. Introduction
2. Materials and Methods
2.1. Fabrication of Metal Parts
2.2. Surface Modification Treatment
2.2.1. Constant Potential Anodizing
2.2.2. Pulsed Wave Potential Anodizing
2.2.3. Thermal Treatment
2.3. Photoelectrochemical Measurements
2.4. Antibacterial Activity Determination
- ΔR is the photocatalytic antibacterial activity with UV irradiation.
- BL is the mean viable number of bacteria in untreated samples after UV irradiation.
- CL is the mean viable number of bacteria in treated samples after UV irradiation.
- BD is the mean viable number of bacteria in untreated samples after incubation in the dark.
- CD is the mean viable number of bacteria in treated samples after incubation in the dark.
3. Results
3.1. Surface Modifications
3.2. Photoelectrocatalytic Properties
3.3. Antibacterial Photocatalytic Evaluation
4. Conclusions
Supplementary Materials
Author Contributions
Funding
Institutional Review Board Statement
Informed Consent Statement
Data Availability Statement
Conflicts of Interest
References
- Browne, M.P.; Redondo, E.; Pumera, M. 3D Printing for Electrochemical Energy Applications. Chem. Rev. 2020, 120, 2783–2810. [Google Scholar] [CrossRef] [PubMed]
- ASM Handbook Committee. Properties and Selection: Nonferrous Alloys and Special-Purpose Materials; ASM International: Materials Park, OH, USA, 1990. [Google Scholar] [CrossRef]
- Agius, D.; Kourousis, K.I.; Wallbrink, C. A Review of the As-Built SLM Ti-6Al-4V Mechanical Properties towards Achieving Fatigue Resistant Designs. Metals 2018, 8, 75. [Google Scholar] [CrossRef]
- Roy, P.; Berger, S.; Schmuki, P. TiO2 Nanotubes: Synthesis and Applications. Angew. Chem. Int. Ed. 2011, 50, 2904–2939. [Google Scholar] [CrossRef] [PubMed]
- Lamberti, A.; Virga, A.; Chiadò, A.; Chiodoni, A.; Bejtka, K.; Rivolo, P.; Giorgis, F. Ultrasensitive Ag-coated TiO2 nanotube arrays for flexible SERS-based optofluidic devices. J. Mater. Chem. C 2015, 3, 6868–6875. [Google Scholar] [CrossRef]
- Lamberti, A.; Garino, N.; Sacco, A.; Bianco, S.; Chiodoni, A.; Gerbaldi, C. As-grown vertically aligned amorphous TiO2 nanotube arrays as high-rate Li-based micro-battery anodes with improved long-term performance. Electrochim. Acta 2015, 151, 222–229. [Google Scholar] [CrossRef]
- Cui, H.; Zhao, W.; Yang, C.; Yin, H.; Lin, T.; Shan, Y.; Xie, Y.; Gu, H.; Huang, F. Black TiO2 nanotube arrays for high-efficiency photoelectrochemical water-splitting. J. Mater. Chem. A 2014, 2, 8612–8616. [Google Scholar] [CrossRef]
- Kuang, D.; Brillet, J.; Chen, P.; Takata, M.; Uchida, S.; Miura, H.; Sumioka, K.; Zakeeruddin, S.M.; Grätzel, M. Application of Highly Ordered TiO2 Nanotube Arrays in Flexible Dye-Sensitized Solar Cells. ACS Nano 2008, 2, 1113–1116. [Google Scholar] [CrossRef] [PubMed]
- Massa, A.; Hernández, S.; Lamberti, A.; Galletti, C.; Russo, N.; Fino, D. Electro-oxidation of phenol over electrodeposited MnOx nanostructures and the role of a TiO2 nanotubes interlayer. Appl. Catal. B Environ. 2017, 203, 270–281. [Google Scholar] [CrossRef]
- He, X.; Cai, Y.; Zhang, H.; Liang, C. Photocatalytic degradation of organic pollutants with Ag decorated free-standing TiO2 nanotube arrays and interface electrochemical response. J. Mater. Chem. 2011, 21, 475–480. [Google Scholar] [CrossRef]
- Ercan, B.; Taylor, E.; Alpaslan, E.; Webster, T.J. Diameter of titanium nanotubes influences anti-bacterial efficacy. Nanotechnology 2011, 22, 295102. [Google Scholar] [CrossRef] [PubMed]
- Baurès, E.; Blanchard, O.; Mercier, F.; Surget, E.; le Cann, P.; Rivier, A.; Gangneux, J.-P.; Florentin, A. Indoor air quality in two French hospitals: Measurement of chemical and microbiological contaminants. Sci. Total Environ. 2018, 642, 168–179. [Google Scholar] [CrossRef] [PubMed]
- Kim, J.H.; Seo, G.; Cho, D.-L.; Choi, B.-C.; Kim, J.-B.; Park, H.-J.; Kim, M.-W.; Song, S.-J.; Kim, G.-J.; Kato, S. Development of air purification device through application of thin-film photocatalyst. Catal. Today 2006, 111, 271–274. [Google Scholar] [CrossRef]
- Lee, H.U.; Park, S.Y.; Lee, S.C.; Seo, J.H.; Son, B.; Kim, H.; Yun, H.J.; Lee, G.W.; Lee, S.M.; Nam, B.; et al. Highly photocatalytic performance of flexible 3 dimensional (3D) ZnO nanocomposite. Appl. Catal. B Environ. 2014, 144, 83–89. [Google Scholar] [CrossRef]
- Mansoorianfar, M.; Tavoosi, M.; Mozafarinia, R.; Ghasemi, A.; Doostmohammadi, A. Preparation and characterization of TiO2 nanotube arrays on Ti6Al4V surface for enhancement of cell treatment. Surf. Coat. Technol. 2017, 321, 409–415. [Google Scholar] [CrossRef]
- Abidi, M.; Hajjaji, A.; Bouzaza, A.; Trablesi, K.; Makhlouf, H.; Rtimi, S.; Assadi, A.A.; Bessais, B. Simultaneous removal of bacteria and volatile organic compounds on Cu2O-NPs decorated TiO2 nanotubes: Competition effect and kinetic studies. J. Photochem. Photobiol. A Chem. 2020, 400, 112722. [Google Scholar] [CrossRef]
- ISO 27447:2009; Fine Ceramics (Advanced Ceramics, Advanced Technical Ceramics) Test Method for Antibacterial Activity of Semiconducting Photocatalytic Materials. International Organization for Standardization (ISO): Geneva, Switzerland, 2009.
- Ge, M.-Z.; Cao, C.-Y.; Huang, J.-Y.; Li, S.-H.; Zhang, S.-N.; Deng, S.; Li, Q.-S.; Zhang, K.-Q.; Lai, Y.-K. Synthesis, modification, and photo/photoelectrocatalytic degradation applications of TiO2 nanotube arrays: A review. Nanotechnol. Rev. 2016, 5, 75–112. [Google Scholar] [CrossRef]
- Wang, G.; Wang, H.; Ling, Y.; Tang, Y.; Yang, X.; Fitzmorris, R.C.; Wang, C.; Zhang, J.Z.; Li, Y. Hydrogen-treated TiO2 nanowire arrays for photoelectrochemical water splitting. Nano Lett. 2011, 11, 3026–3033. [Google Scholar] [CrossRef] [PubMed]



| PP | CP | TT | |
|---|---|---|---|
| No Light | ![]() | ![]() | ![]() |
| Near UV-Light | ![]() | ![]() | ![]() |
| ∆R | 1.2 | 0.4 | 2.4 |
Disclaimer/Publisher’s Note: The statements, opinions and data contained in all publications are solely those of the individual author(s) and contributor(s) and not of MDPI and/or the editor(s). MDPI and/or the editor(s) disclaim responsibility for any injury to people or property resulting from any ideas, methods, instructions or products referred to in the content. |
© 2023 by the authors. Licensee MDPI, Basel, Switzerland. This article is an open access article distributed under the terms and conditions of the Creative Commons Attribution (CC BY) license (https://creativecommons.org/licenses/by/4.0/).
Share and Cite
Arcas, R.; Martín, L.; Ibiza, S.; Jordá, O.; Bosch, F.; Valero-Gómez, A. Surface Treatments on Additively Manufactured Ti6Al4V Parts for the Formation of Photocatalytic Nanostructured Surfaces with Antibacterial Properties. Mater. Proc. 2022, 11, 4. https://doi.org/10.3390/materproc2022011004
Arcas R, Martín L, Ibiza S, Jordá O, Bosch F, Valero-Gómez A. Surface Treatments on Additively Manufactured Ti6Al4V Parts for the Formation of Photocatalytic Nanostructured Surfaces with Antibacterial Properties. Materials Proceedings. 2022; 11(1):4. https://doi.org/10.3390/materproc2022011004
Chicago/Turabian StyleArcas, Ramón, Lucía Martín, Sales Ibiza, Olga Jordá, Francisco Bosch, and Ana Valero-Gómez. 2022. "Surface Treatments on Additively Manufactured Ti6Al4V Parts for the Formation of Photocatalytic Nanostructured Surfaces with Antibacterial Properties" Materials Proceedings 11, no. 1: 4. https://doi.org/10.3390/materproc2022011004
APA StyleArcas, R., Martín, L., Ibiza, S., Jordá, O., Bosch, F., & Valero-Gómez, A. (2022). Surface Treatments on Additively Manufactured Ti6Al4V Parts for the Formation of Photocatalytic Nanostructured Surfaces with Antibacterial Properties. Materials Proceedings, 11(1), 4. https://doi.org/10.3390/materproc2022011004